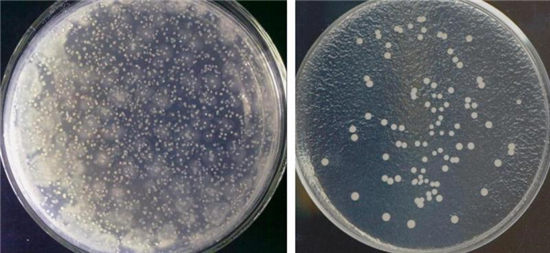
1.jpg

内外部要分别用不同的擦拭材料清洁卫生,随后还要用消毒溶液进行消毒,自然晾干或烘干。7月11日,国内首个餐饮配送箱(包)消毒标准发布,并于当日起正式实施。今后,不仅企业消毒配送箱不再仅靠感官判断是否卫生,同时职能部门也有了检测依据。
菌落总数指标严于纸巾
7月11日,中国烹饪协会携手起草单位饿了么、百度外卖发布了《消毒餐饮配送箱(包)》这一协会团体标准,这也是也是该类标准中首个全国性标准。
近年来,网络餐饮平台发展规模呈急速发展态势,配送环节食品安全越来越受到消费者关注。
国家食品药品监督管理总局正在制定《网络订餐监督管理办法》,其征求意见稿中就有相关的内容,如送餐人员应当保持个人卫生,使用安全、无害的配送容器,并保持容器清洁。而在某些城市已经开始实施的地方立法中,已经有了规定。比如2016年9月1日起实施的《上海市网络餐饮服务监督管理办法》规定,使用的送餐箱或者送餐包应当定期清洁、消毒。
饿了么高级食品安全专家、消毒餐饮配送箱标准起草组专家苗虹表示,在梳理国内外相关法规和标准的基础上,起草单位通过严谨细致的科学实验研究,对消毒剂的选择、消毒效果评价指标及具体标准值的设定,进行了认真研究。
记者注意到,此次发布的消毒餐饮配送箱(包)标准主要包括感官指标和微生物限量指标。其中微生物限量指标明确:大肠菌群不得检出,菌落总数小于100 CFU/cm2。这个数量是个什么概念?是我国法规规定的纸巾表面菌落总数合格指标的一半。通俗地讲,就是送餐箱消毒后的内环境应该比纸巾更干净。
上图为:消毒前(左)后(右)菌落总数测定示意图(每100平方厘米)。
中烹协将向行业推广宣贯
那么送餐箱具体该如何消毒和监测?标准中也有详细的规定。饿了么、百度外卖的送餐小哥今天也进行了现场演示:清洗前先戴上一次性手套,转移出保温材料等物品;用湿纸巾或者一次性纸巾沾自来水(或)洗涤剂溶液清洗餐饮配送箱(包)的内外表面,为避免交叉污染,小哥对内外表面进行了分别清洗,而内部清洗时还特别注意容易藏污纳垢的四角处。“如使用材料进行擦拭清洗,应保证擦拭材料清洁卫生”,在一旁解说的苗虹表示,为避免二次使用污染,不建议使用毛巾清洗擦拭,而是使用一次性纸巾或者湿纸巾;如使用含有表面活性剂的洗涤剂溶液清洗或擦拭,应用自来水去除洗涤剂残留。
在消毒环节,两个快递小哥使用了含氯消毒剂溶液和酒精消毒,采用喷雾方式,使餐饮配送箱(包)内表面全部湿润,不过前者作用时间为30分钟,酒精消毒作用时间为3分钟,自然晾干,最后擦拭时,也要确保擦拭材料清洁卫生。
对于消毒的频率问题,苗虹表示,目前饿了么是每天消毒一次。记者了解到,该标准由饿了么携手百度外卖作为该标准的起草单位,在中国烹饪协会指导下最终确立出台。该标准将被推荐给中烹协成员单位旗下几百万餐饮门店。中烹协将在未来两个月内对会员企业推广宣贯这一标准。
业内专家表示,标准的发布和实施将有助于规范配送工具的清洗消毒,提升网络餐饮配送环节食品安全水平,在提供快捷便利的送餐服务的同时,保障消费者餐饮安全,也可以为职能部门的执法检查提供依据。